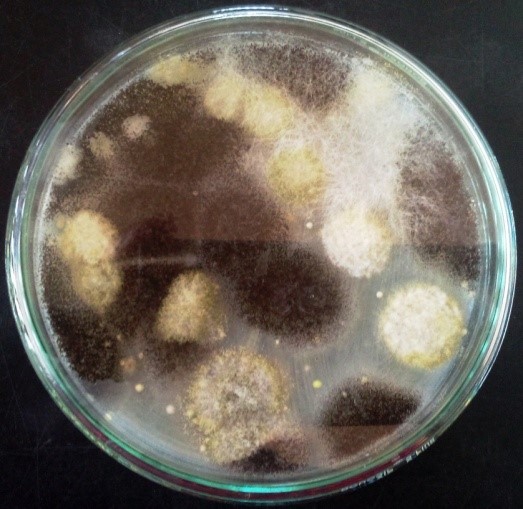

TRI-BIOTECH introduces a range of online certificate course on various latest cutting end research techniques. These courses are specially designed to build and enhance critical professional skills needed to your successful research career
✔ Learn online courses on your own time at your place!
✔ No travel required!
✔ Challenging assignments and exams for better understanding!
✔ Live practical demonstration!
✔ Certification will be provided!
✔ Enrol two online 10 days courses and get one online crash course free!
✔ Choose your topic from the following!
✔ Enquire for more details!
✔ Submit your application today! Registration

We are happy to introduce the online-based certification course in cell culture techniques! It will help the students, scholars and faculties from both academia and industries can utilize their lockdown time in a beneficial way!!
Cell culture is an important technique for studying the normal physiology and biochemistry of cells. In order to understand an organism, it is important to understand how its cells work. Through cell culture, this becomes possible. Whatever is learned about the cells in vitro is representative of what is happening to the organism/tissue. This makes cell culture significantly important for vaccine development, screening (drugs etc), and diagnosis of given diseases/conditions. Having a good understanding of what the procedure is meant to achieve, it becomes easier to prepare the culture with the right components.
Scope of the course
This certificate course is designed to prepare you to understand the laboratory cell culture techniques. You’ll also learn basic methods for passaging, freezing, thawing cultured cells, laboratory set-up, safety, and aseptic techniques, etc. Upon the successful completion of this course, you will have a basic understanding of the principles and practice of cell culture that you can immediately apply to your research projects.
Topics to be Covered:
1. Maintenance of cultures (adherent and suspension, primary cells, etc)
2. Transfection
3. Determination of cell growth and viability
4. Mycoplasma testing
5. Isolation of Primary cells (PBMCs)
6. MTT assay
7. Preparation of media and types
7. Preparation of media and types
9. Cell count and viability (trypan blue)
10. Determination of confluency
11. Importance of Tissue culture
12.Importance of sterility and types of sterilizationy
13. Do's & don'ts in a Tissue culture lab
14. Applications of Cells/Tissue culture
15. Freezing and revival of cells
Duration: 10 days
Eligibility:
Students with Lifesciences backgrounds, Faculties from Academia and Industries (M.Sc., B.Tech., M.Tech., M.Phil., B.Pharm., M.Pharm., B.E., M.E., M.D., and Ph.D., etc)
Scoring pattern:
Assignment submission on-time – 50 %
Examination – 35 %
Active participation in learning – 15 %
Course Fee For Students: Rs. 2500/-
others: Rs. 3500/-
Mode of study
*Completely online mode of study
Cell culture lessons with practical experiments and question papers will be sent through your email ID. Online webinar will be conducted weekly once with live demonstrations.
For more details contact us
Cell: 9944977828 / 9585622639
E. Mail: contacttrcbt@gmail.com